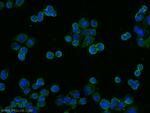
IL22RA1 Antibody in Immunocytochemistry (ICC/IF)

Search
Proteintech
IL22RA1 Polyclonal Antibody
{{$productOrderCtrl.translations['antibody.pdp.commerceCard.promotion.promotions']}}
{{$productOrderCtrl.translations['antibody.pdp.commerceCard.promotion.viewpromo']}}
{{$productOrderCtrl.translations['antibody.pdp.commerceCard.promotion.promocode']}}: {{promo.promoCode}} {{promo.promoTitle}} {{promo.promoDescription}}. {{$productOrderCtrl.translations['antibody.pdp.commerceCard.promotion.learnmore']}}
产品信息
13462-1-AP
种属反应
已发表种属
宿主/亚型
分类
类型
抗原
偶联物
形式
浓度
规格
纯化类型
保存液
内含物
保存条件
运输条件
产品详细信息
Immunogen sequence: YVTKPPAPP NSLNVQRVLT FQPLRFIQEH VLIPVFDLSG PSSLAQPVQY SQIRVSGPRE PAGAPQRHSL SEITYLGQPD ISILQPSNVP PPQILSPLSY APNAAPEVGP PSYAPQVTPE AQFPFYAPQA ISKVQPSSYA PQATPDSWPP SYGVCMEGSG KDSPTGTLSS PKHLRPKGQL QKEPPAGSCM LGGLSLQEVT SLAMEESQEA KSLHQPLGIC TDRTSDPNVL HSGEEGTPQY LKGQLPLLSS VQIEGHPMSL PLQPPSRPCS PSDQGPSPWG LLESLVCPKD EAKSPAPETS DLEQPTELDS LFRGLALTVQ WES (253-574 aa encoded by BC029273)
靶标信息
A novel cytokine, designated IL-TIF for IL-10 related T cell-derived inducible factor and IL-22, was recently identified. The receptor for IL-22 (IL-22R, also termed CRF2-9 and IL-TIF-R1 chain) is a new member of the class II cytokine receptor family. IL-22R forms a complex with IL-10 receptor beta chain and mediates IL-22 signaling. IL-22 and its receptor activate JAK-STAT signaling pathway. IL22R is expressed in normal liver and kidney and their cell lines HepG2 and TK-10. A soluble form of IL-22 receptor, also termed IL-22 binding protein (IL-22BP) and IL-22 receptor-alpha 2 (IL-22RA2), was identified very recently. IL-22BP prevents binding of IL-22 to the functional cell surface IL-22R complex and neutralizes IL-22 activity. LPS induces IL-22 expression, which indicates the role of IL-22 in inflammatory response.
仅用于科研。不用于诊断过程。未经明确授权不得转售。
生物信息学
蛋白别名: CRF2-9; cytokine receptor; Cytokine receptor class-II member 9; Cytokine receptor family 2 member 9; il-22 receptor; IL-22 receptor subunit alpha-1; IL-22R-alpha-1; IL-22RA1; ILN; Interleukin; interleukin 22 receptor, alpha 1; interleukin-22 receptor alpha chain; Interleukin-22 receptor subunit alpha-1; unnamed protein product; ZcytoR11
基因别名: 9130219A07Rik; CRF2-9; ENSMUSG00000073746; IL-22R; IL22R; IL22R1; IL22RA1; RGD1559655
UniProt ID: (Human) Q8N6P7, (Mouse) Q80XZ4
Entrez Gene ID: (Human) 58985, (Mouse) 230828, (Rat) 362629